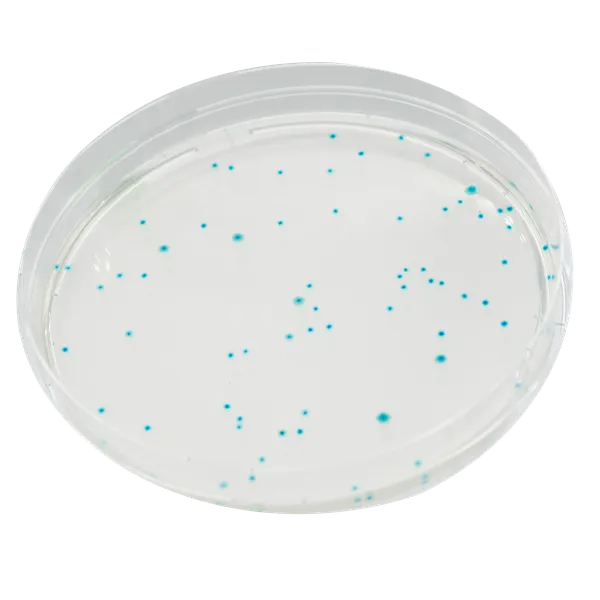
CHROMagar™ E.coli

Hình thái khuẩn lạc

E. coli
xanh dương
Hiệu năng
Hiệu năng
Nhiễm bẩn bởi vật liệu phân từ động vật có thể được phát hiện thông qua việc phát hiện Escherichia coli trong mẫu. E. coli có thể làm ô nhiễm nước uống khi hệ thống xử lý nước không đủ hoặc trong các thời kỳ mưa rất lớn. Việc giám sát sản xuất thực phẩm và nước là rất quan trọng. Nhiễm bẩn cao có thể dẫn đến việc đình chỉ cung cấp nước hoặc thu hồi thực phẩm bởi các siêu thị.
Liên quan đến nước tắm, các quy định ngày càng nghiêm ngặt hơn:
• Chỉ thị của Châu Âu từ năm 1976: 2.000 vi khuẩn Escherichia coli (E. coli) cho 100 mL nước.
• Chỉ thị mới năm 2006: 500 E. coli mỗi 100 mL.
Sự có mặt của E. coli cho thấy sự nhiễm bẩn phân và sự hiện diện tiềm tàng của các tác nhân gây bệnh nguy hiểm như vi khuẩn như Vibrio cholerae, Salmonella, Pseudomonas, hoặc virus và ký sinh trùng đường ruột. Các nhiễm trùng kết quả từ việc tiêu thụ vật liệu bị nhiễm có thể nguy hiểm và đe dọa tính mạng.
4. Chất lượng: Môi trường CHROMagar™ E.coli chứa 5% thạch nhiều hơn các môi trường khác trên thị trường. Điều này giúp đáng kể trong việc áp dụng và đi mẫu lên đĩa. Môi trường này cũng phù hợp cho kỹ thuật lọc màng hoặc kỹ thuật rót đĩa.
2. Dễ đọc và diễn giải: Tiêu chuẩn chung cho thực phẩm và nước thường dao động từ 0 đến số ít đếm E. coli CFU trên mỗi gram và do đó việc phát hiện và đếm chính xác là quan trọng. Với CHROMagar™ E. coli, khuẩn lạc của E. coli phát triển với màu xanh đậm, do đó làm cho việc phát hiện và đếm chỉ số vệ sinh quan trọng này dễ dàng nhất có thể.
3. Giảm khối lượng công việc:Các phương pháp phát hiện truyền thống E. coli rất tẻ nhạt và tốn nhiều công sức, đòi hỏi phải nghiên cứu nhiều khuẩn lạc.
Thành phần

Tài liệu kỹ thuật
Công bố khoa học
1996
Dénombrement de Escherichia coli au moyen de géloses chromogènes sélectives - comparaison avec la méthode officielle.
? Publication1979
Patent Application - Chromogenlc chemical substrates for identification of microbial colonies
? Publication

Xem thêm